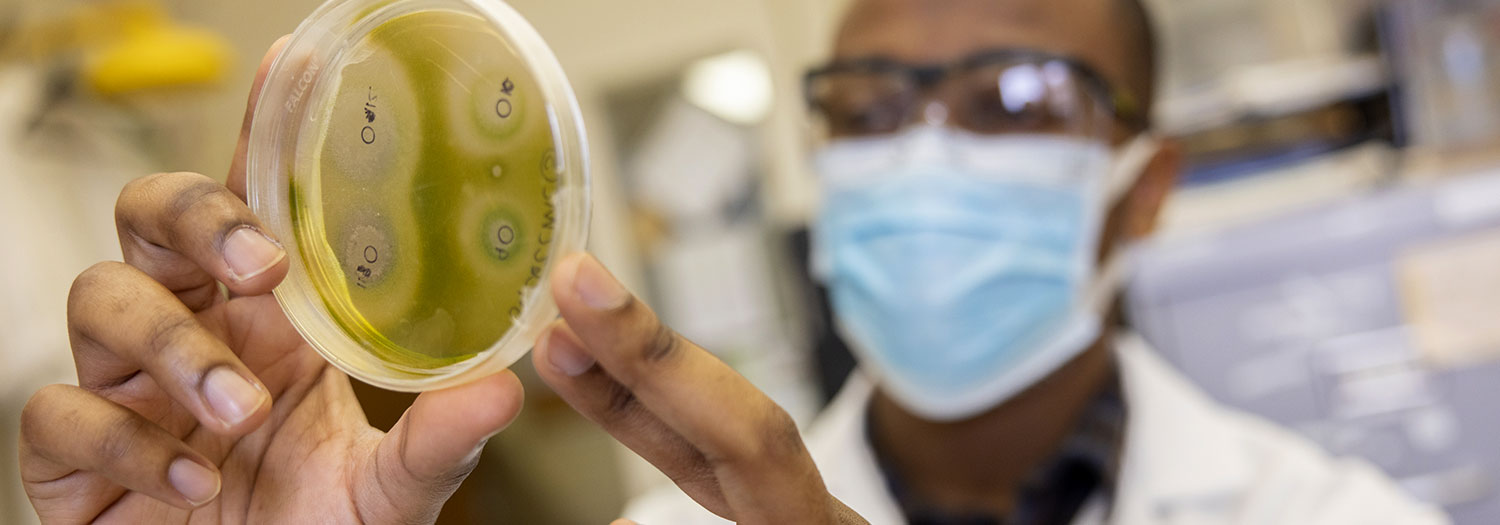

- Office of Student Engagement and Experiential Learning
- Funding Opportunities
- Undergraduate Research Funding
Undergraduate Research Funding
Undergraduate research has been identified by the Association of American Colleges and Universities as a high-impact practice. We promote faculty to engage with students in this evidence-based practice as it has shown to improve student outcomes and increase learning success.
Student Engagement Fund
The Student Engagement Fund (SEF) is an Office of Student Engagement and Experiential Learning (OSEEL) coordinated funding program that provides undergraduate student stipends and project supply funds for faculty-mentored research/artistry and community-based projects. Projects in the College of Liberal Arts and Sciences (CLAS) are funded in partnership with the college.
Faculty from all colleges and disciplines are encouraged to apply for funding. SEF typically funds projects that fit under the following categories:
- Research and Artistry: Research/artistry project meant to contribute to a body of knowledge on a specific topic, intended to serve the academic community, and controlled by the researcher or artist.
- Civic Engagement: Projects that promote and consider ways citizens are active, engaged, and informed as it relates to political participation, education, and other societal issues.
- Community-engaged Research: NIU defines community engagement as an intentional collaboration between partners who unite their expertise and resources in a shared vision for the public good. Community-based research is a collaborative model that involves community members most likely to be impacted by the research outcomes in the research process.
- Funding Decisions
- Acceptable Use of Funds
- Timeline
- Eligbility and Requirements
- Disbursement of Funds
Funding Decisions
Applications eligible for funding communicate an intentional, well-developed plan to actively engage students in the research process and implement high quality mentorship practices to support the growth, development, and skills of undergraduate researchers in inclusive research environments. Applications that demonstrate a strong commitment and plan for overall student development and inclusivity, specifically recruitment strategies and mentoring practices that prioritize reducing environmental barriers, fare well during the review process. Faculty representatives on the Committee for the Improvement of the Undergraduate Academic Experience (CIAUE) will screen applications.
The following priorities and commitments are considered when making final funding decisions:
- Engaging students from a wide range of experiences, perspectives, and backgrounds in the research and knowledge creation process
- Providing opportunities for students underrepresented in their fields
- Providing funding to faculty from historically underfunded disciplines that have a lack of external funding opportunities
- Need for OSEEL funding to facilitate the student experience
OSEEL has funding partners across the University. Funding partners make award decisions based on their funding priorities.
Acceptable Use of Funds
The main purpose of SEF is to increase the number of undergraduate students receiving funding to participate in research.
In addition to funding for student researchers, faculty can apply for project supply expenses. Eligible project supply expenses include:
- Materials and supplies specific to the project
- Research Participant Compensation in accordance with NIU Policy
- Direct project expenses (copying, mailing surveys, etc…)
Travel Expenses
- Research-related travel expenses (travel to a research/field site and lodging)
SEF does not cover travel costs for conferences for students to present or attend professional conferences. Students interested in presenting their faculty-mentored research are encouraged to submit a Conference Travel Funding application.
CLAS faculty facilitating group field site and experiential learning experiences as part of course requirements should reach out directly to their college to request funds.
Limitations
You may limit the project timeline to one semester or extend it across multiple semesters during the application cycle (summer, fall, and spring). The following limitations will apply:
- Faculty submits one application per project, for a maximum of two applications per faculty member.
- Each faculty member, regardless of whether they are submitting one or two applications, is limited to a maximum of $3,800 in SEF support per year, divided as follows:
- $2,400 in student researcher funds
- $1,000 in project supply funds
- $400 in research-related travel expenses
Faculty have the option of dividing the funds per semester and hiring full-time or part-time undergraduate researchers. As such, the maximum funding outlined above can be divided as follows:
- Student researchers: maximum of $2,400 per year.
- Full-time researcher: $1,200 per semester
- Part-time researcher: $600 per semester
- Project supplies: maximum of $1,000 per year
- Full-time researcher: $500 per student
- Part-time researcher: $250 per student
- Research-related travel expenses: maximum of $400 per year
- Full-time researcher: $200 per student
- Part-time researcher: $100 per student
Funding Timeline
- Application opens: mid-January
- Application deadline: end of February
- Awardees notified: early April
- Faculty-student learning agreement: two weeks prior to the start of the semester
Eligibility and Requirements
Student Eligibility
In order for students to receive a stipend as an undergraduate researcher, the following criteria must be met:
- Currently enrolled student at NIU
- In good academic standing
- Full time researchers must be able to contribute 10 hours per week, on average and part time researchers 5 hours per week, on average
Program Requirements
Faculty and students will be added to OSEEL’s Research Funding Programs Blackboard organization which will be used to communicate program requirements and expectations.
Students
- Meet with faculty to complete student-faculty mentor learning agreement and adhere to established commitments
- Maintain regular communication with your faculty mentor
- Submit monthly progress reports
- Complete end of project survey
- Present your research project at NIU’s annual Conference on Undergraduate Research and Engagement (CURE)
Faculty Mentors
- Meet with student and use the student-faculty mentor learning agreement to establish expectations
- Meet with student periodically to assess and review the stated learning outcomes of the project outlined in the student-faculty mentor learning agreement
- Provide resources and necessary tools for students
- Ensure students have completed any necessary safety training to participate in the project. Students and staff can create an account to access Collaborative Institutional Training Initiative (CITI training)
- Maintain regular communication with your student researcher and OSEEL staff on any major changes with the research project or mentoring relationship
- Review student abstract and presentation content for CURE
- Work with your department office/business manager to order awarded project supplies
Disbursement of Funds
Stipends
Stipends for OSEEL undergraduate researchers will be processed through your bursar account and disbursed into partial payments throughout your project on the 15th of each month. If you already have a direct deposit account with the Bursar’s Office, please contact them to make sure you have the correct bank account on file for your funding to be distributed. Direct deposit as an NIU employee is not the same. You will still need to set up this feature through the Bursars office. Visit go.niu.edu/DirectDeposit for more information and to sign up for direct deposit.
Travel
Student Travel
Individual conference travel awards will be processed through MyScholarships. You will receive an email from MyScholarships with your awarded amount. Once you receive this email, you must accept the award. Upon acceptance, the award will be disbursed to your account within 10-14 business days.
Faculty Travel
Faculty awarded travel funds through the Experiential Learning Group Travel grant will complete the NIU Request for Group Travel advance form. Within two weeks of return from travel, a travel advance form must be completed with detailed, itemized receipts and submitted to Accounts Payable to reconcile the advance.
Taxability Statement Notice for Stipends
Please note that stipend payments for this award, though not considered wages, may be considered taxable income. The Internal Revenue Service regulations and notices state that the payer (Northern Illinois University) of a taxable stipend payment is not required to withhold income tax and not required to report the payment to the student at calendar year-end. Therefore, stipend payments issued to students who are U.S. citizens, permanent residents, or resident aliens (for U.S. tax purposes) will not be reported on IRS Form 1099-MISC at the end of the calendar year. Students are responsible for reporting these payments and remitting any tax due. Please refer to IRS Pub. 970, Tax Benefits for Education, for additional information. It is recommended you consult a qualified tax advisor to assist with personal tax questions.
Contact Us
Office of Student Engagement and Experiential LearningHolmes Student Center 264-266
engage@niu.edu